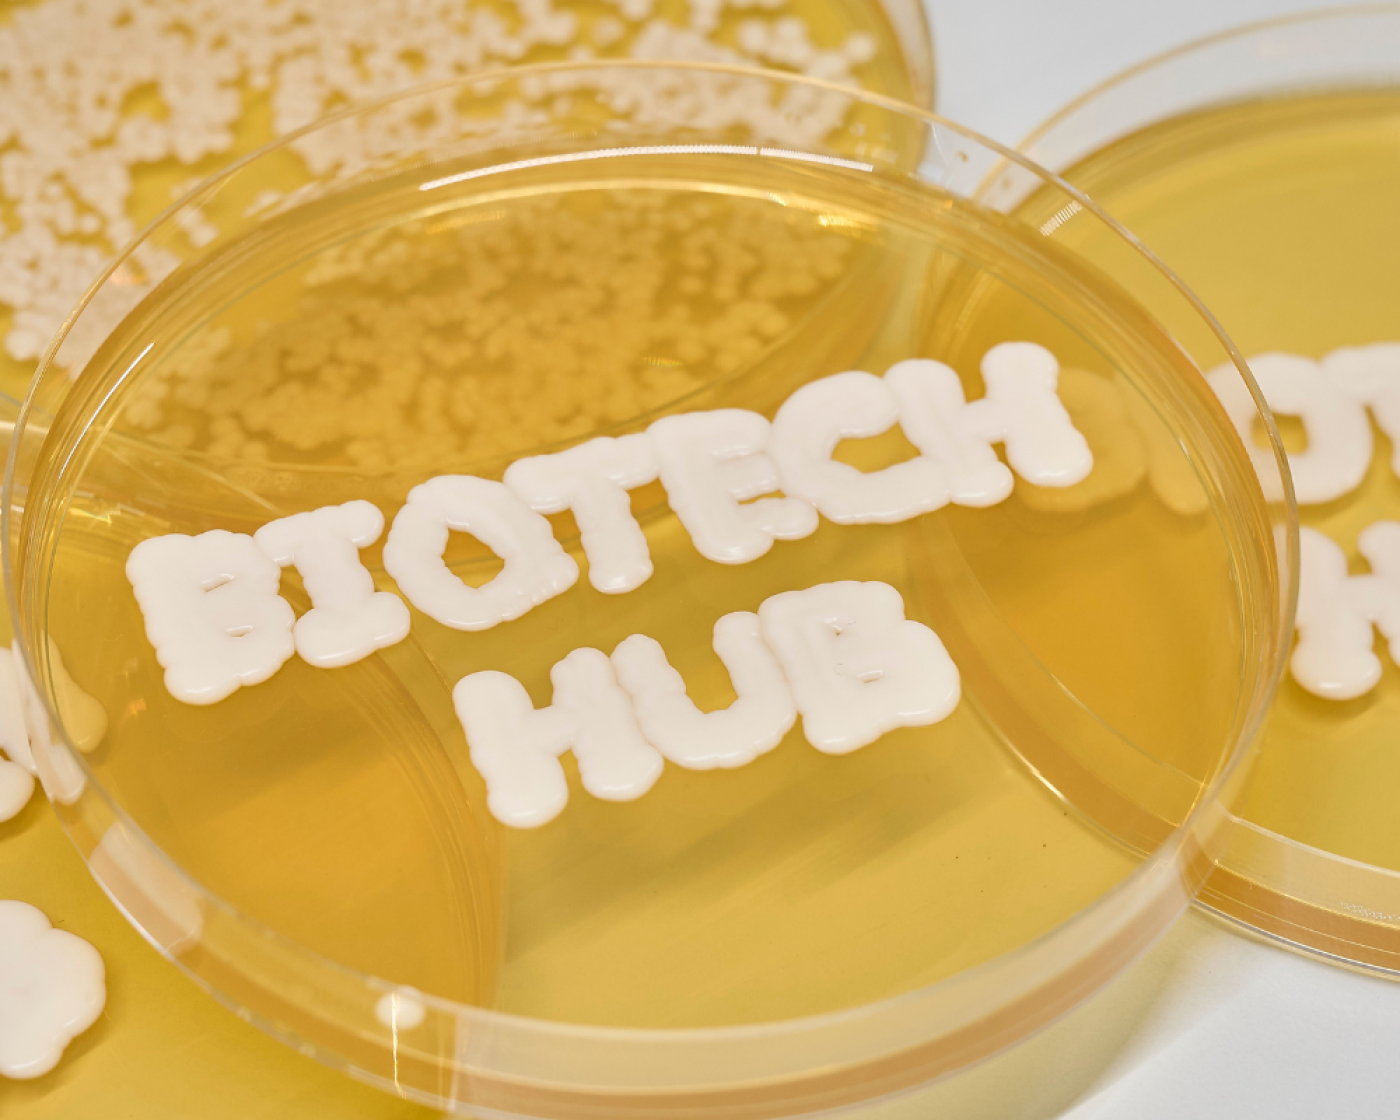

Wir leben Innovation
Der 1.000 Quadratmeter große Biotech-Hub von GELITA wurde im Jahr 2022 innerhalb von nur einem Jahr im Industriepark Höchst fertiggestellt. In diesem hochmodernen Biotech-Labor entwickeln und verbessern wir Mikroorganismen, die zur Produktion von organischen Verbindungen wie Proteinen verwendet werden können. Dies stellt einen wichtigen Schritt für das Unternehmen in Zukunftsmärkte dar. Der Fokus liegt hierbei auf nicht-tierischen Kollagenproteinen für Anwendungen in der Kosmetik, Nahrungsergänzung, Pharmazie und Medizinprodukten.
Ihre Karrierechancen in unserem Biotech Hub
In unserem Biotech Hub haben Sie die Möglichkeit, einen Schritt weiter zu gehen, Innovationen hautnah zu erleben und umzusetzen.
Unser Biotech-Hub bietet eine Vielzahl von Karrieremöglichkeiten in den Bereichen Bioprozessentwicklung, Stammzellenentwicklung, Downstream-Verarbeitung und Analytik.
Wir bieten verschiedene Einstiegsmöglichkeiten, z.B. als:
- Wissenschaftler:in
- Teamleiter:in
- Laborleiter:in
Bitte sprechen Sie uns auf Möglichkeiten für eine Tätigkeit als Werkstudent:in oder für eine Zusammenarbeit als Partnerunternehmen für Ihre Abschlussarbeit an.